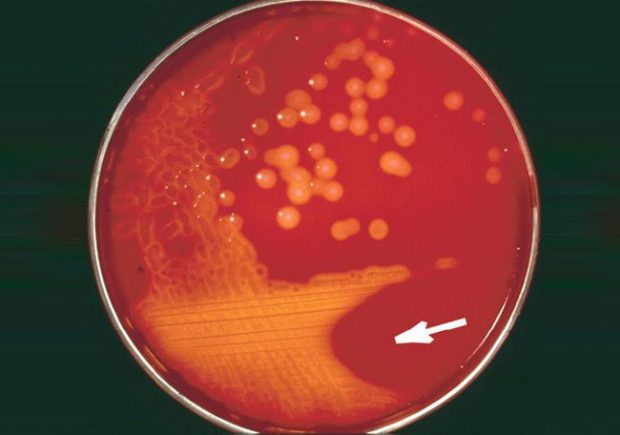

Los expertos del ANLIS-Malbrán además comprobaron que la bacteria no ha adquirido genes que le confieran mayor virulencia y/o transmisibilidad que la habitual
La Secretaría de Gobierno de Salud de la Nación confirmó que al momento no existe brote epidémico de la bacteria Streptococcus pyogenes de acuerdo a los resultados a los que arribó la Administración Nacional de Laboratorios e Institutos de Salud (ANLIS) “Dr. Carlos G. Malbrán”, luego de analizar las muestras recibidas de Streptococcus Pyogenes los días 12 y 13 de septiembre pasado en el Instituto Nacional de Enfermedades Infecciosas dependiente de esta ANLIS.
Como sostienen los especialistas del laboratorio de referencia, el análisis del genoma demostró que en todos los casos estudiados hasta la fecha, la bacteria no ha adquirido genes que le confieran mayor virulencia y/o transmisibilidad que la habitual y que los aislamientos analizados presentaron diferentes perfiles toxigénicos, confirmando que no se encontraron ni genética ni epidemiológicamente relacionados.
Cabe mencionar que el repentino y brusco aumento de infecciones invasivas en muchas regiones del mundo está asociado a la emergencia de clones hipervirulentos, los del tipo emm 1 son definidos por la producción abundante de numerosas exotoxinas.
El análisis del viruloma del grupo de aislamientos de Streptococcus Pyogenes estudiados por Secuenciación total de genoma, el cual incluyó los casos correspondientes a la semana 36 y casos de enfermedad invasiva del segundo semestre de 2017 y primer trimestre de 2018, indica que, hasta la fecha, no hay evidencia de la emergencia de una variante más agresiva de esta bacteria en nuestro país.
